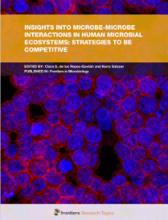

Bifidobacterium longum
Global patented Bifidobacterium strain with
inhibition of rotavirus infection of infants

-
모유수유한 건강한 아기의
분변으로부터 분리 -
US FDA GRAS 등재
GRN No.813 -
한국 미생물 보존센터 균주 기탁
KCCM 10492 -
유전자 염기서열 구축
미국 국립 생물 공학 센터
GenBank No. CP031133
Global
Notifications
USA

NDI
(New Dietary Ingredient) approved by FDA [NDI 1082]
USA

GRAS
(Generally Recognized As Safe) approved by FDA [GRN 000813]
USA

Patented strain probiotics.
KOREA

Patented strain probiotics.
KOREA

Halal certificate recognized by Korea Muslim Federation Halal Committee.
Europe

Recognized by the European Food Safety Authority with Qualified Presumption of Safety (QPS)
Australia

Included in “Approved Terminology for Medicines Section – Biological List” by TGA
Canada

Can be used as Medicinal Ingredients of Natural Health Product
CHINA

Recognized by CFDA used in food
Featured in
book chapters
모유수유 영아에게서 나온 B. longum BORI는 그것이 지니고 있는 건강증진 효과에 대해서는 대학과 병원의 다양한 연구진들이 진행한 임상적 증거에 관해 잘 입증되어 있으며, 국제 미생물학 교과서들에도 소개되어 있습니다.

Encyclopedia of Food and Health

Bergey's Manual of
Systematic Bacteriology:
Volume 5: The Actinobacteria
The Bifidobact
eria and Related Organisms

Advances in Nutraceutical
Applications in Cancer

Carbohydrate-Active
Enzymes
Global
application

More
References
Certificate
- • Non-GMO
- • BSE-free
- • TSE-free
- • No Allergen
- • Halal Certi
Packaging
- • 1kg / pack
- • 10pack/box
Safety
- • US FDA GRAS approved
- • US FDA NDI approved
- • Whole Genome Sequencing
- • 30 years without side effect
Storage Condition
Be kept in an airtight container
and stored at a temperature not
exceeding 8℃




